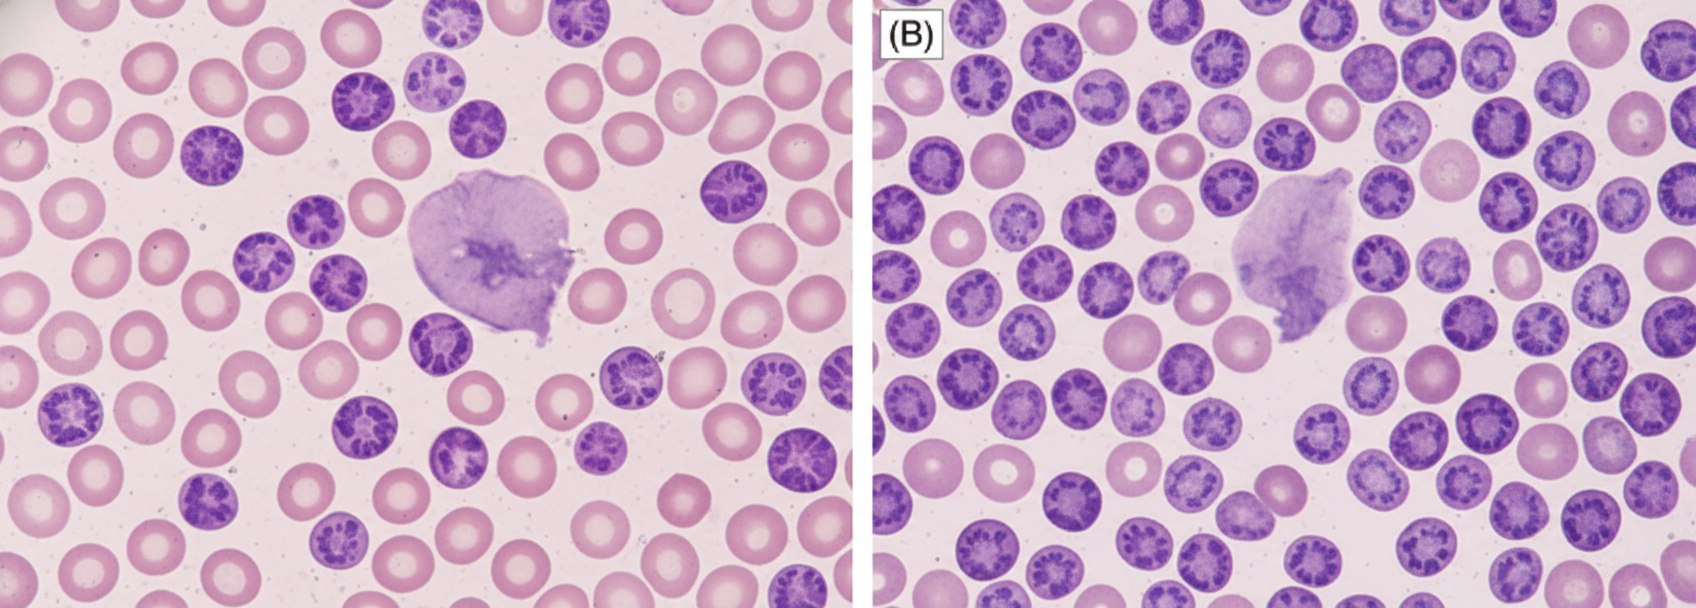
Image for question 11

Enter your email to get your 85% OFF code and unlock the full NEET PG question bank on the app.
A 10-year-old child with Valvular heart disease on heart failure treatment, has the following ECG tracing. What is the diagnosis?

A 50-year-old woman with rheumatic heart disease is on medication for heart disease. She feels unwell for most part of the day. Which of the following medicine is responsible for the ECG changes shown below? (Recent NEET Pattern 2016-17)

A 60-year-old hypertension patient presents with breathlessness. ECG was performed. What is the diagnosis? (Recent NEET Pattern 2016-17)

A 50-year-old smoker comes with complaints of ankle edema for last 3 months. The ECG shows all except: (Recent NEET Pattern 2016-17)

The patient with the following hematological abnormality presents with severe chest pain and difficulty in breathing. All are useful for managing this emergency except:

The pattern of inheritance of the hematological disorder shown is:

A 70-year-old man presents with painless cervical lymphadenopathy with progressive pallor and petechiae on ankles. Peripheral smear shows presence of:
The following bone marrow specimen is suggestive of diagnosis of:

A 12-year-old child with renal tubular acidosis type I is having muscle cramps and weakness. ECG shows all except:

A 3-year-old child presents with the clinical features shown in the image. What is the most likely diagnosis?
